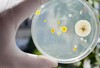

Д-р Ангел Мавровски за огнището на антракс в Силистренско: Случаят е особено опасен
focus-news.net(преди 16 часа)10 публикации

Огнище на антракс беше установено в Силистренско. Животните са лекувани около 30 дни от ветеринарен лекар на обекта, без да бъдат уведомени компетентните власти и без да е била ясна диагнозата. ФОКУС припомня, че вчера установиха огнище на антракс в силистренското село Черногор. ...
Прочети в focus-news.netВсички публикации (10)

Д-р Ангел Мавровски за огнището на антракс в Силистренско: Случаят е особено опасенОгнище на антракс беше установено в Силистренско. Животните са лекувани около 30 дни от ветеринарен лекар на обекта, без да бъдат уведомени компетентните власти и без да е била ясна диагнозата. ФОКУС припомня, че вчера установиха огнище на антракс в силистренското село Черногор. Става дума за ферма ...

БАБХ потвърди случай на антракс във ферма с биволи в силистренско селоОгнище на антракс е установено във ферма с 28 бивола в силистренското село Черногор, съобщиха от Българската агенция по безопасност на храните (БАБХ). Наличието на заболяването е лабораторно потвърдено. Девет животни са умрели, останалите ще бъдат ваксинирани. Към този момент няма данни за заразени ...

БАБХ потвърди антракс в СилистренскоОгнище на антракс е установено във ферма с 28 биволи в с. Черногор, Силистренско, съобщиха от Българската агенция за безопасност на храните (БАБХ). Заболяването е лабораторно потвърдено. Девет животни са умрели, останалите ще бъдат ваксинирани. Към този момент няма данни за заразени хора. Регионална...

БАБХ установи огнище на антракс в силистренското село ЧерногорБългарската агенция по безопасност на храните (БАБХ) установи огнище на антракс във ферма с 28 биволи в силистренското село Черногор, съобщават от пресцентъра на агенцията. Наличието на заболяването е лабораторно потвърдено. Девет животни са умрели, останалите ще бъдат ваксинирани. Към този момент н...

БАБХ потвърди случай на антракс в село край СилистраОгнище на антракс е установено във ферма с 28 биволи в с. Черногор, Силистренско. Наличието на заболяването е лабораторно потвърдено. Девет животни са умрели, останалите ще бъдат ваксинирани. Към този момент няма данни за заразени хора. Регионалната здравна инспекция (РЗИ) е уведомена и извършва про...

БАБХ потвърди случай на антракс в с. Черногор, СилистренскоОгнище на антракс е установено във ферма с 28 биволи в с. Черногор, Силистренско. Наличието на заболяването е лабораторно потвърдено. Девет животни са умрели, останалите ще бъдат ваксинирани. Към този момент няма данни за заразени хора. Регионалната здравна инспекция (РЗИ) е уведомена и извършва про...

Огнище на антракс в Силистренско: БАБХ запечата незаконни обекти за месоОгнище на антракс е установено във ферма в с. Черногор, Силистренско. Девет от общо 28 бивола в стопанството вече са умрели, а инфекцията е потвърдена лабораторно. Останалите животни ще бъдат спешно ваксинирани, като към момента няма данни за заразени хора. Проверката на Българската агенция по безоп...

БАБХ потвърди случай на антракс във ферма с биволи в силистренското село ЧерногорОгнище на антракс е установено във ферма с 28 бивола в силистренското село Черногор, съобщиха от Българската агенция по безопасност на храните (БАБХ). Наличието на заболяването е лабораторно потвърдено. Девет животни са умрели, останалите ще бъдат ваксинирани. Към този момент няма данни за заразени ...
Огнище на антракс в Силистренско: БАБХ запечата незаконни обекти за месоОгнище на антракс е установено във ферма с 28 биволи в с. Черногор, Силистренско. Наличието на заболяването е лабораторно потвърдено. Девет животни са умрели, останалите ще бъдат ваксинирани. Към този момент няма данни за заразени хора. Регионалната здравна инспекция (РЗИ) е уведомена и извършва про...

БАБХ потвърди случай на антракс в село край СилистраОгнище на антракс е установено във ферма с 28 биволи в с. Черногор, Силистренско. Наличието на заболяването е лабораторно потвърдено. Девет животни са умрели, останалите ще бъдат ваксинирани. Към този момент няма данни за заразени хора. Регионалната здравна инспекция (РЗИ) е уведомена и извършва про...
